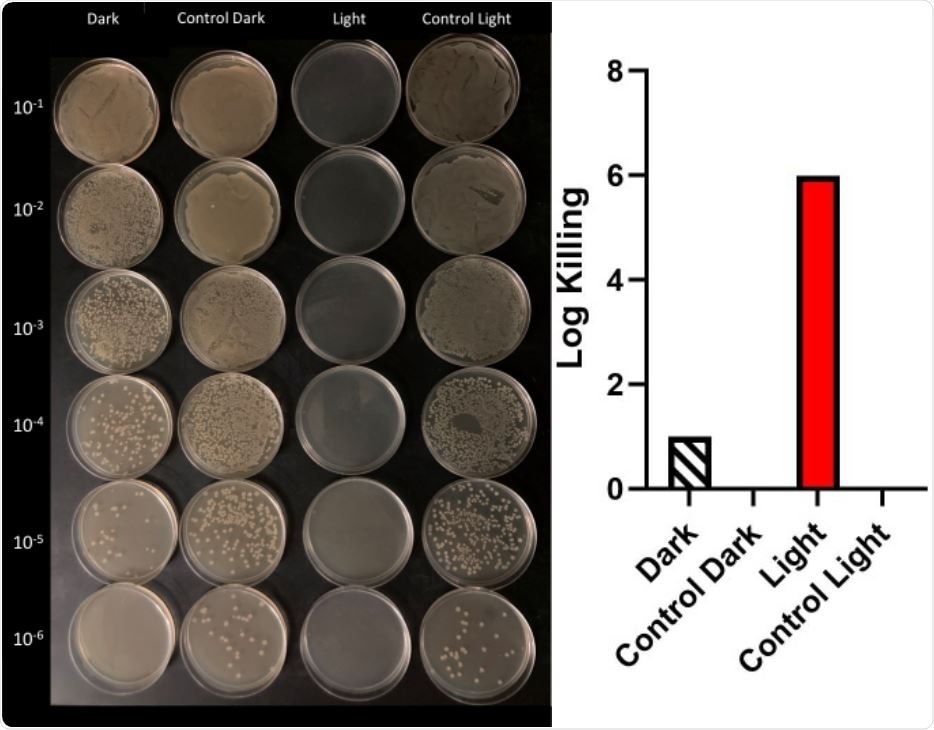
Cell counting of serial dilutions of E. coli. Under irradiation of 10 μg/mL of compound 1 with visible light and in dark (above, left) and graphical representations of log kills in dark and light. There was no killing on irradiation (Control Light) and dark control (Control Dark) samples.

Coronavirus disease 2019 (COVID-19) emerged in late December 2019 in Wuhan, China. With few treatments, a rapid transmission rate, and high mortality amongst at-risk groups such as the elderly, the disease quickly grew into a pandemic, spreading to nearly every country by the end of 2020.
The pandemic has resulted in more than 4.9 million deaths, and many governments have been forced to enact harsh restrictions in an effort to prevent more spread, causing global economic crises.
While mass vaccination schemes appear to be beginning to help control the disease, there are still relatively few treatments available. While there was widespread media attention around hydroxychloroquine and ivermectin, neither showed any effectiveness in respected clinical trials.
Monoclonal antibody treatments have shown some small improvements in patients, but may contribute to immune cell infection. Recent studies have indicated certain statins may be effective in reducing mortality, but this has not been confirmed.
Scientists from the University Of New Mexico have recently identified a new cationic oligomer that may help inactivate severe acute respiratory syndrome coronavirus 2 (SARS-CoV-2).
A preprint version of the group’s study is available on the bioRxiv* server, while the article undergoes peer review.
The researchers identified that oligomers of poly-phenylene ethynylene act as powerful antiviral agents. They showed that non-enveloped viruses that attack Escherichia coli could display antiviral activity under both light-activation and dark treatment with several different cationic oligomers and polyelectrodes. However, when scientists developed antimicrobial reagents based on these principles, they discovered that they only showed effectivity against SARS-CoV-2 when activated by ultraviolet or visible light.
The materials they developed included a set of cationic polyphenylene-ethynylenes and polythiophenes and smaller cationic and anionic oligomers. They assumed the lack of ability to inactivate SARS-CoV-2 under dark treatment was due to the viral envelope of SARS-CoV-2.

Top: functional components of end-only functionalized oligomers. Structures of 1 and 2 used in this study are shown below.

 This news article was a review of a preliminary scientific report that had not undergone peer-review at the time of publication. Since its initial publication, the scientific report has now been peer reviewed and accepted for publication in a Scientific Journal. Links to the preliminary and peer-reviewed reports are available in the Sources section at the bottom of this article. View Sources
This news article was a review of a preliminary scientific report that had not undergone peer-review at the time of publication. Since its initial publication, the scientific report has now been peer reviewed and accepted for publication in a Scientific Journal. Links to the preliminary and peer-reviewed reports are available in the Sources section at the bottom of this article. View Sources
While the materials cannot penetrate this envelope, they still engage in a ground state docking process that enables the formation of a singlet of oxygen from the excited tripler of the oligomer. This singlet oxygen may be able to penetrate further into the virus.
The most straightforward effective material was an end-only OPE (EO-OPE-1), where the chromophore and charged groups could be easily tuned. After creating two OPEs with different charged end groups, they found that the second was not soluble in water, making it difficult to use and test.
The other OPE, Oligomer 1, was initially tested against Escherichia coli, before advancing to SARS-CoV-2. Initially, the log reduction in Escherichia coli concentration (log kill) was examined with oligomer 1 at concentrations of 10ug/mL, 1ug/mL, and 0.1ug/mL with 5, 10, and 30 minutes of irradiation time. Control experiments showed no killing of Escherichia coli in the control dark or with the white lamp alone. At 10ug/mL, oligomer 1 proved effective at killing Escherichia coli no matter the irradiation time, while at 1ug/mL, irradiation of 10 minutes or over was required. At 0.1ug/mL, no killing was observed even at 30 minutes of irradiation.
Dark conditions with any concentration also showed very little killing. However, when these tests were repeated on paper and glass fiber filters, a final concentration of 10ug/mL again showed significant inactivation – proving the molecule could prove effective when adsorbed to a support structure.
Further experiments using SARS-CoV-2 rather than Escherichia coli showed again significant log killing under light conditions, with 3 logs, or 99.9% of the virus inactivated, after 5 minutes exposure at 10ug/mL.
Cell counting of serial dilutions of E. coli. Under irradiation of 10 μg/mL of compound 1 with visible light and in dark (above, left) and graphical representations of log kills in dark and light. There was no killing on irradiation (Control Light) and dark control (Control Dark) samples.
The successful killing of viruses and bacteria while adsorbed to filters should allow the material to be used in air or water decontamination systems.
The authors highlight the importance of their discoveries in helping to eliminate SARS-CoV-2 on surfaces, hastening the end of the pandemic.
While the toxicity of the material and the need for visible light irradiation prevents the use of the oligomer as a treatment, the ability of the oligomer to kill both SARS-CoV-2 and Escherichia coli while mounted on a support suggests it would be very useful in filtration devices, or on wipes to help ensure sterility in commonly touched areas.

 This news article was a review of a preliminary scientific report that had not undergone peer-review at the time of publication. Since its initial publication, the scientific report has now been peer reviewed and accepted for publication in a Scientific Journal. Links to the preliminary and peer-reviewed reports are available in the Sources section at the bottom of this article. View Sources
This news article was a review of a preliminary scientific report that had not undergone peer-review at the time of publication. Since its initial publication, the scientific report has now been peer reviewed and accepted for publication in a Scientific Journal. Links to the preliminary and peer-reviewed reports are available in the Sources section at the bottom of this article. View Sources
Journal references:
- Preliminary scientific report.
Kaya, K. et al., (2021) Rapid and Effective Inactivation of SARS-CoV-2 by a Cationic Conjugated Oligomer with Visible Light: Studies of Antiviral Activity in Solutions and on Supports. bioRxiv. doi: https://doi.org/10.1101/2021.10.18.464882, https://www.biorxiv.org/content/10.1101/2021.10.18.464882v1
- Peer reviewed and published scientific report.
Kaya, Kemal, Mohammed Khalil, Benjamin Fetrow, Hugh Fritz, Pradeepkumar Jagadesan, Virginie Bondu, Linnea Ista, et al. 2022. “Rapid and Effective Inactivation of SARS-CoV-2 with a Cationic Conjugated Oligomer with Visible Light: Studies of Antiviral Activity in Solutions and on Supports.” ACS Applied Materials & Interfaces 14 (4): 4892–98. https://doi.org/10.1021/acsami.1c19716. https://pubs.acs.org/doi/10.1021/acsami.1c19716.